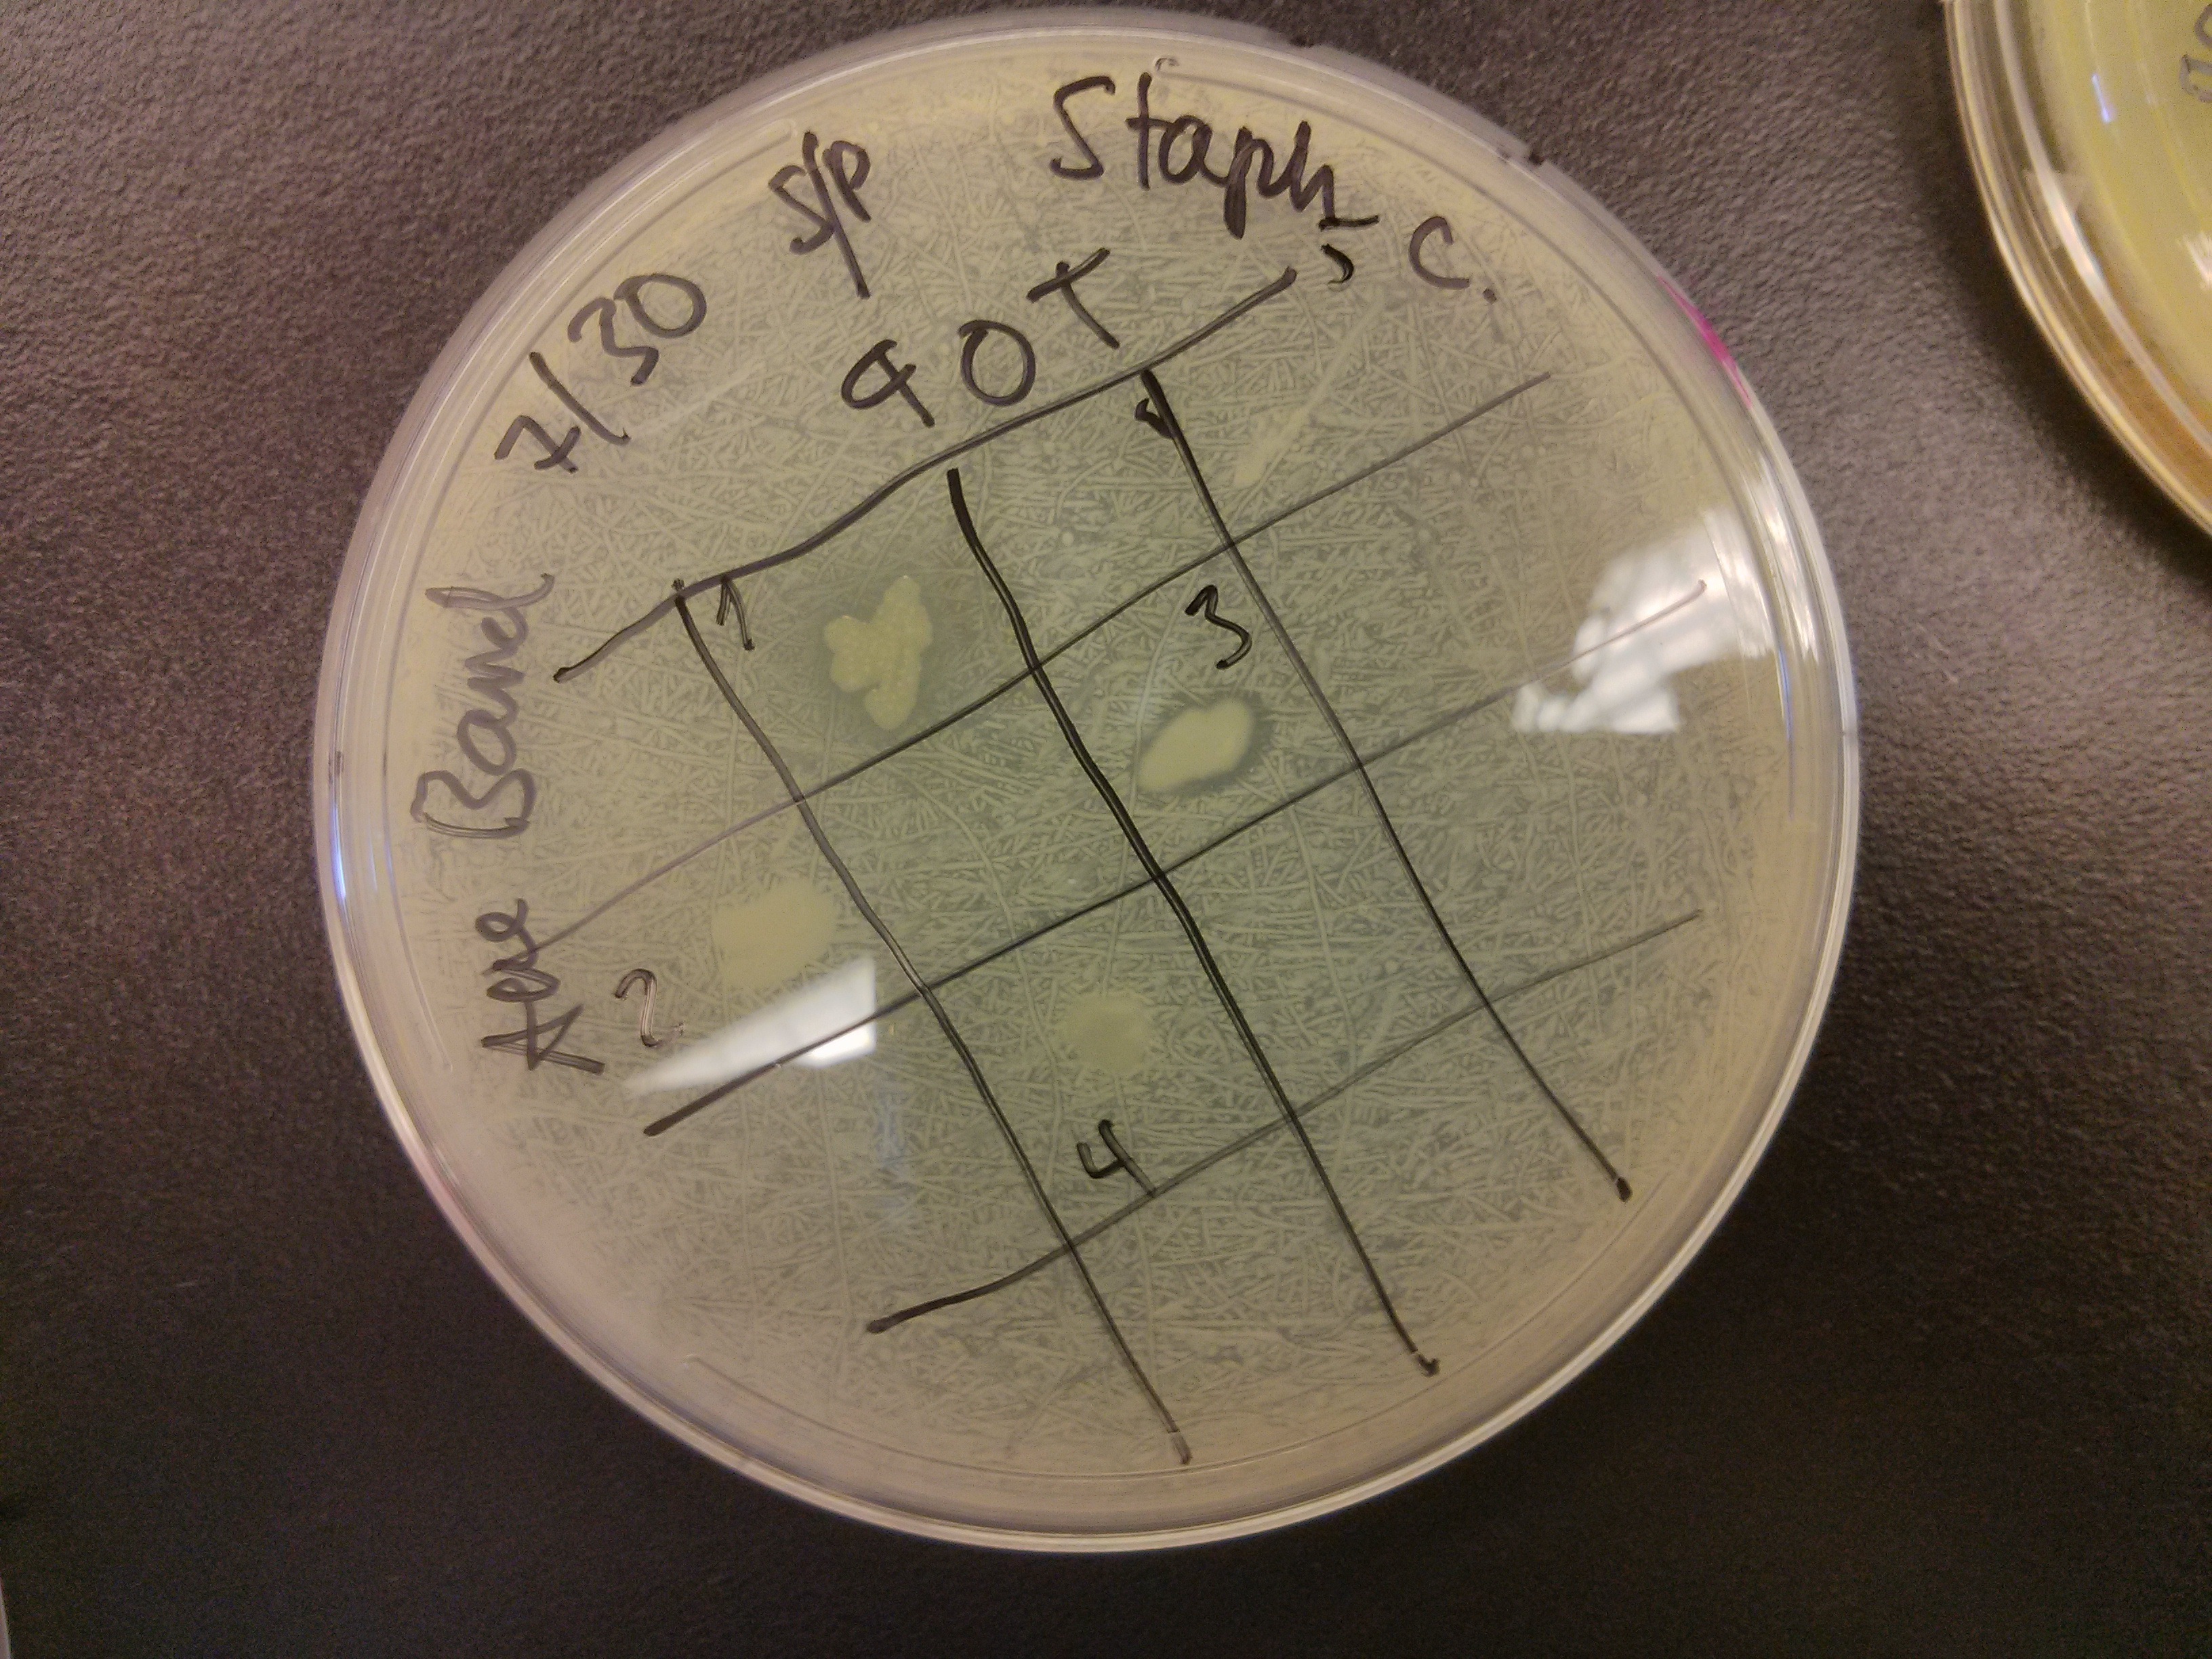

The Small World Initiative workshop has been galloping rapidly for the past 4 days. The group (24 biology educators from a variety of institutions) recreate the activities that students are to do in the prospective research course. The soil sample spread on the plates produced a number of colonies, pale bacterial ones that later became yellow or even fluorescent, intermingled with a haphazardly growing mucous bacillus whose name I have forgotten. We picked and patched, making master plates; and then spread and patched, confronting our colonies with harmless relatives of ESKAPE organisms (Enterococcus, Klebsiella, Pseudomonas, Acinetobacter, Staph, Enterobacter). We got all excited when discovering zones of inhibition, we retested, Gram-stained, did colony PCR to make a 16s sequencing, extracted with organic solvents, and as of today, we are eagerly awaiting the results of a spot assay of the aqueous phase against one of the bad guys.
Most of our time, however, is spent either in small groups developing our learning goals and objectives, as well as assessments; or sitting in a very cold big room to learn more about backward design, diversity, or IRB forms. The rest of the time we eat, and drink copious amounts of coffee or tea.
To make things more interesting, Jo Handelsman just became nominated for the position of Associate Director for Science, Office of Science and Technology Policy of the Administration. It is to the team’s credit that in spite of the news and all possible changes this may cause, things keep running smoothly. As smoothly as possible with 20 something scientists packed in a lab playing with microbes while learning new techniques. The course methodology incorporates such a variety of techniques, that most of us have something to learn.
The blog site I referred before is closed now for participants only, as we are uploading our working documents. There will be an official website with all the bells and whistles coming out in the near future.
Besides the workshop curriculum, we are learning lots from each other. We exchange ideas and tips, show each other techniques, software, apps, and tricks we use in research and teaching. I installed MEGA yesterday thanks to my roommate, and have been happily making little phylogenetic trees. Can’t wait for the sequence of my two finalists to come out.
And that is all for today. In a small scale (our workshop) we are having fun doing science and are worrying about how to make it happen home. In the large scale it is fun to think that somebody who knows science and science education well will be in such a high and responsible position. Personally, I hope that we are reaching a tipping point, where the powers to be realize that science education HAS to change and adapt to the realities of our century.
Is it time for dinner so soon?

Leave a comment